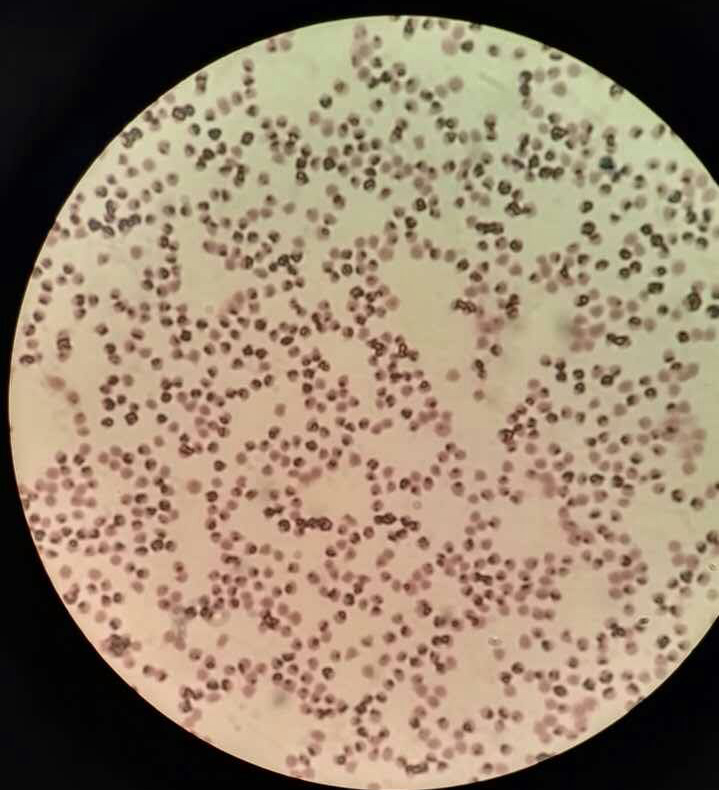
山羊寄生虫病症状,山羊癞病怎么治

山羊梨形虫病的诊治
黑山羊养殖是山区脱贫致富的一项重要产业,但养殖中如何做好一些重要疫病的防治,对养羊业健康发展尤为重要。小编将陆续作介绍。
梨形虫病也叫焦虫病,是由泰勒科和巴贝斯科的各种梨形虫引起,其中山羊泰勒虫是使山羊发病的主要病原体。该病病程缓慢,前期不易发觉,后期死亡率高,多为散发或呈小范围流行,对养羊业危害严重。
症状:病羊年龄在8个月至3.5岁之间,食欲下降,精神不佳,呼吸急促,心跳加快,3只病羊体温升39.2—41.3℃,3只成年羊尿液颜色呈棕红色;5只病羊眼结膜轻度黄疸,多数病羊喜卧,上坡无力,6只病羊下痢;病羊极度消瘦。

病羊尿呈血红色
剖检:剖检当时死亡病羊1只和濒死病羊1只,见病羊消瘦,肩前淋巴结、胃肠道淋巴结肿大,胆囊出血明显,胆汁为红色,胃肠粘膜有点状出血。肺脏气肿、变性,颜色苍白,表面有针尖大出血点。

患病后期的病羊
实验室诊断:采集5只病羊耳静脉血,染色镜检,发现有羊泰勒焦虫,虫体胞浆呈淡蓝色,核呈暗红色,位于虫体边缘;虫体多为圆形或卵圆形。

血中的梨形虫
红细胞中可见梨形虫
防治:本病的传播媒介是蜱。在防治上,应该先灭蜱,对圈舍内墙面、缝隙应定期喷洒药物灭蜱,在蜱大量寄生的夏秋季节注意杀灭体表蜱。药物可用2—3%敌百虫溶液喷洒,或药浴。对严重的病羊,选用盐酸吖啶黄注射液(规格10ml×50mg),每千克体重0.2ml静注,严重者24小时后重注一次,同时早晚补给病羊精料。治疗25只,死亡4只,治愈率84%。